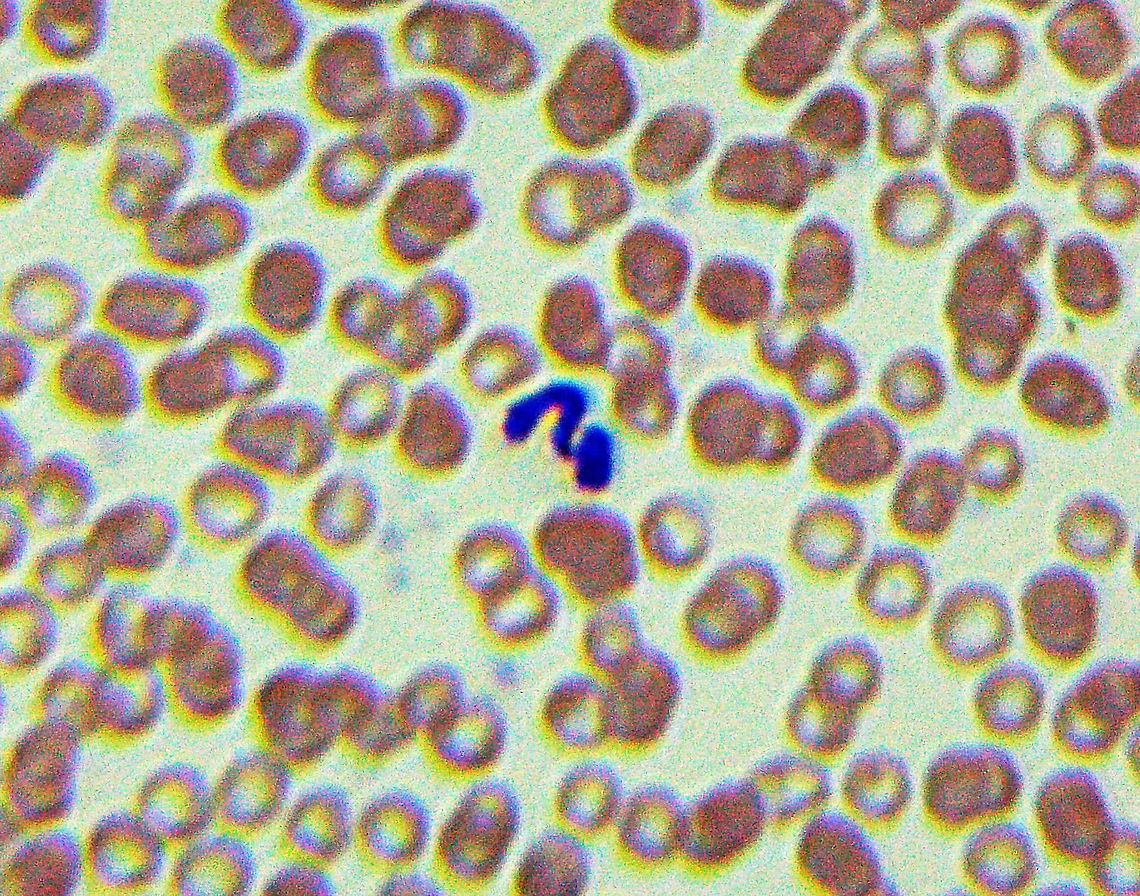
Dog Heartworm - Dirofilaria immitis The blue squiggle on this slide is Dirofilaria immitis, which causes dog heartworm. It infects the lung arteries and heart of its host, eventually leading to death. The definitive host is the dog, but it can also infect other animals such as cats, foxes, and bears. It is transmitted by mosquitoes in the genera Aedes, Culex, Anopheles, and Mansonia.<br />
<br />
There are numerous drugs available to prevent infection.<br />
<br />
*Slide is a blood smear  Dirofilaria,Dirofilaria immitis,Geotagged,Onchocercidae,United States,Winter,arthropod-borne disease,dirofilariasis,dog heartworm,filarial worm,heartworm,parasitic roundworm,roundworm

Dog Heartworm - Dirofilaria immitis
The blue squiggle on this slide is Dirofilaria immitis, which causes dog heartworm. It infects the lung arteries and heart of its host, eventually leading to death. The definitive host is the dog, but it can also infect other animals such as cats, foxes, and bears. It is transmitted by mosquitoes in the genera Aedes, Culex, Anopheles, and Mansonia.
There are numerous drugs available to prevent infection.
*Slide is a blood smear

''Dirofilaria immitis'', also known as heartworm or dog heartworm, is a parasitic roundworm that is a type of filarial worm, a small thread-like worm, that causes dirofilariasis. It is spread from host to host through the bites of mosquitoes.